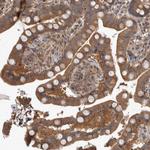
IFRD1 Antibody in Immunohistochemistry (Paraffin) (IHC (P))

Search
Invitrogen
IFRD1 Polyclonal Antibody
{{$productOrderCtrl.translations['antibody.pdp.commerceCard.promotion.promotions']}}
{{$productOrderCtrl.translations['antibody.pdp.commerceCard.promotion.viewpromo']}}
{{$productOrderCtrl.translations['antibody.pdp.commerceCard.promotion.promocode']}}: {{promo.promoCode}} {{promo.promoTitle}} {{promo.promoDescription}}. {{$productOrderCtrl.translations['antibody.pdp.commerceCard.promotion.learnmore']}}
产品信息
PA5-54985
种属反应
宿主/亚型
分类
类型
抗原
偶联物
形式
浓度
规格
纯化类型
保存液
内含物
保存条件
运输条件
RRID
产品详细信息
Immunogen sequence: AKVDKRKQRS VFRDVLRAVE ERDFPTETIK FGPERMYIDC WVKKHTYDTF KEVLGSGMQY HLQSNEFLRN VFELGPPVML DAATLK
Highest antigen sequence identity to the following orthologs: Mouse - 97%, Rat - 95%.
靶标信息
Tis7, also known as IFRD1, is a 442 amino acid containing membrane associated, non-nuclear intracellular protein belonging to the IFRD family. A regulatory protein expressed in a variety of tissues, Tis7 is known to play an important role in the regulation of gene activity in the proliferative and/or differentiative pathways induced by NGF. Reports suggest that Tis7 may be an autocrine factor that attenuates or amplifies the initial ligand induced signal and might also augment the adaptive response by stimulating the production of differentiated enterocytes. Tis7 acts as a negative regulator of transcriptional activity and represses expression of genes involved in myogenesis, muscle maintenance, and regeneration in a histone deacetylase dependent manner.
仅用于科研。不用于诊断过程。未经明确授权不得转售。
篇参考文献 (0)
生物信息学
蛋白别名: 12-O-tetradecanoylphorbol-13-acetate-induced sequence 7; Interferon-related developmental regulator 1; Nerve growth factor-inducible protein PC4; pheochromocytoma cell-4; TPA induced sequence 7; unnamed protein product
基因别名: IFRD1; PC4; TIS7
UniProt ID: (Human) O00458
Entrez Gene ID: (Human) 3475